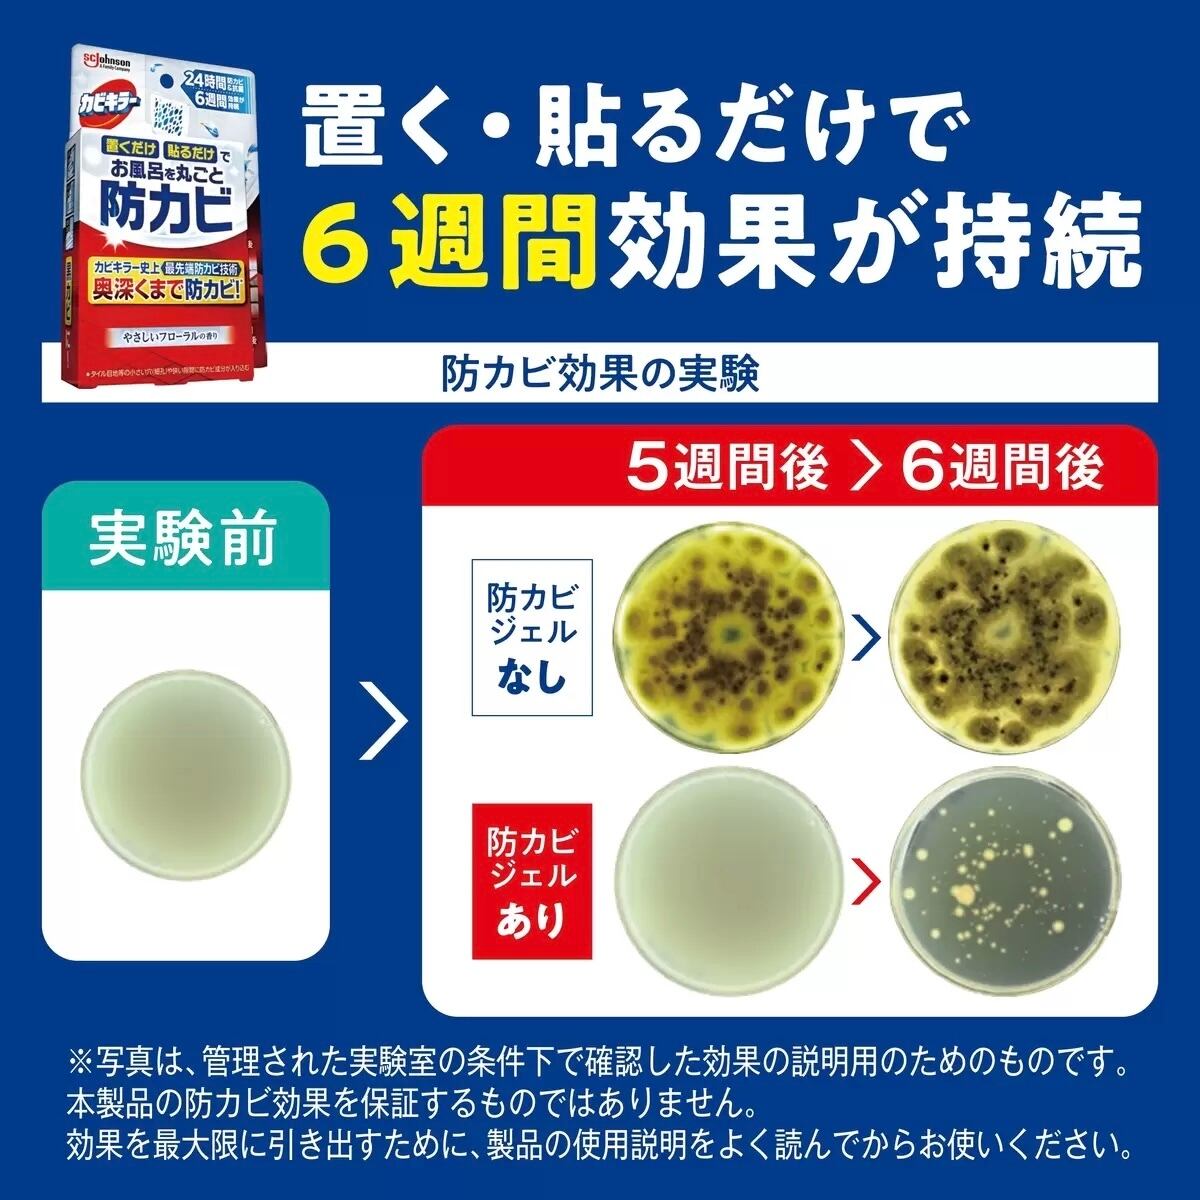

配送方法を必ず確認してください!
店舗受け取り希望の方はQ&Aをご覧ください!





1/5
お風呂丸ごと防カビ 本体+替5P
¥3,642
(商品の特徴)
•置くだけ・貼るだけでお風呂を丸ごと防カビ&抗菌!
•カートリッジを交換するだけで、取り換えも簡単!
•やさしいシトラスの香り
カビキラー史上最先端の防カビ技術で、タイル目地等の小さな穴(細孔)や狭い隙間の奥に潜むカビ菌にまで作用。
カラシナ種子から抽出したエッセンシャルオイルを防カビ成分として配合し、6週間(※1)防カビ・抗菌し続ける! ※1 使用環境により異なります。
最近チェックした商品
同じカテゴリの商品
セール中の商品
その他の商品
Category